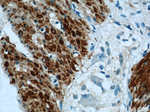
Alpha cardiac muscle actin Antibody in Immunohistochemistry (Paraffin) (IHC (P))
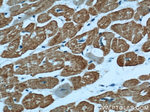
Alpha cardiac muscle actin Antibody in Immunohistochemistry (Paraffin) (IHC (P))

Search
Proteintech
Alpha cardiac muscle actin Polyclonal Antibody
{{$productOrderCtrl.translations['antibody.pdp.commerceCard.promotion.promotions']}}
{{$productOrderCtrl.translations['antibody.pdp.commerceCard.promotion.viewpromo']}}
{{$productOrderCtrl.translations['antibody.pdp.commerceCard.promotion.promocode']}}: {{promo.promoCode}} {{promo.promoTitle}} {{promo.promoDescription}}. {{$productOrderCtrl.translations['antibody.pdp.commerceCard.promotion.learnmore']}}
产品信息
23082-1-AP
种属反应
宿主/亚型
分类
类型
抗原
偶联物
形式
浓度
纯化类型
保存液
内含物
保存条件
运输条件
产品详细信息
Immunogen sequence: MCDDEETTA LVCDNGSGLV KAGFAGDDAP RAVFPSIVGR PRHQGVMVGM G (1-50 aa encoded by BC009978)
靶标信息
ACTC1 are part of actins, which are highly conserved proteins that are involved in various types of cell motility. Polymerization of globular actin (G-actin) leads to a structural filament (F-actin) in the form of a two-stranded helix. Each actin can bind to four others. The protein encoded by this gene belongs to the actin family which is comprised of three main groups of actin isoforms, alpha, beta, and gamma. The alpha actins are found in muscle tissues and are a major constituent of the contractile apparatus. Defects in this gene have been associated with idiopathic dilated cardiomyopathy (IDC) and familial hypertrophic cardiomyopathy (FHC).
仅用于科研。不用于诊断过程。未经明确授权不得转售。
生物信息学
蛋白别名: actin alpha cardiac; Actin, alpha cardiac muscle 1; Alpha-cardiac actin; alphac-actin
基因别名: ACTC; Actc-1; ACTC1; ASD5; CMD1R; CMH11; LVNC4
UniProt ID: (Human) P68032, (Mouse) P68033
Entrez Gene ID: (Human) 70, (Mouse) 11464